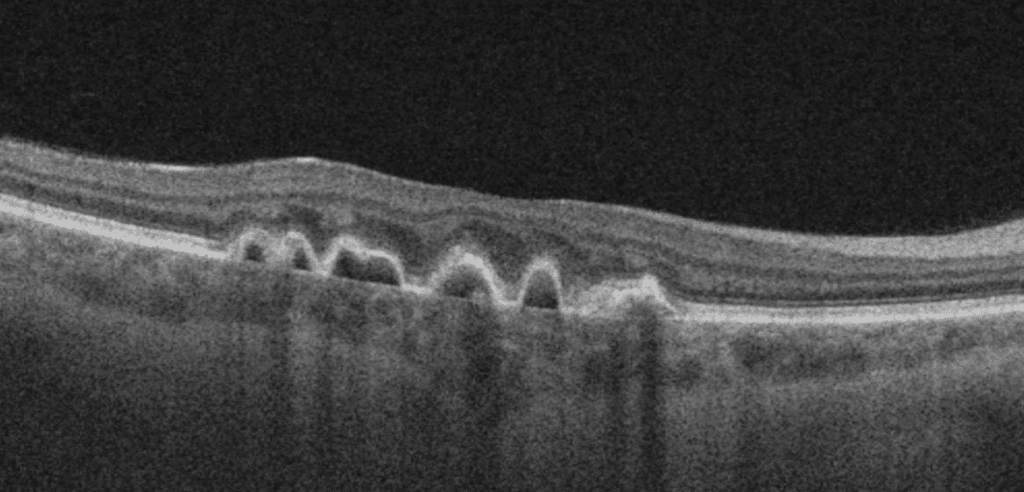

¹: University of Manitoba, Department of Ophthalmology

Case:
A 48-year-old female patient was referred by her optometrist for assessment of dry age-related macular degeneration. She had noted a gradual and painless decrease in her near and distance vision for several years alongside longstanding stable floaters. She denied photophobia, scotoma, and metamorphopsia, and had no history of other ocular diseases or previous ocular surgery. Her family ocular history was unremarkable. Past medical history was remarkable for renal disease secondary to glomerulonephritis which was diagnosed and treated with systemic steroids 10 years prior to her current presentation.
On examination, she had a best corrected visual acuity of 20/20 vision in both eyes. Intraocular pressures were normal and the anterior segment examination was unremarkable. Posterior examination revealed retinal pigment epithelium (RPE) mottling and pigment epithelial detachments (PED) in the macular region as well as nasally in both eyes. Fundus findings were symmetric in both eyes (see Figure A-D). Optos ultra-widefield imaging revealed macular RPE mottling with PEDs in the macula and nasally (see Figure A). Ultra-widefield fundus autofluorescence demonstrated hypoautofluorescent areas with hyperautofluorescent borders in the macula with hyperautoflourescent spots nasally (see Figure B). Macular optical coherence tomography (OCT) scans of both eyes showed PEDs with Bruch’s membrane thickening along with sub-RPE drusen-like deposit (see Figure C).
Discussion:
We report a case of a rare but intriguing association between glomerulonephritis and RPED. The association of RPE alterations with glomerulonephritis was first reported in 1989 by Duvall-Young et al.1
The pathophysiological link between glomerulonephritis and retinal findings remains unknown; however, it has been proposed that immune complex deposition and systemic inflammation characteristic of glomerulonephritis may extend to affect the basement membranes of the RPE and cause breakdown and detachment of RPE.2 PED may also occur in association with serous retinal detachments in hemodialytic patients.2
The location of retinal drusen found in glomerulonephritis patients is similar to glomerular deposits found in subepithelial regions. In addition, their composition from complement components and immunoglobulins show similarity to drusen in age-related macular degeneration in location and composition.3
Multimodal imaging of the retina can help identify early retinal manifestations of glomerulonephritis associated retinopathy. This may enable diagnosis of glomerulonephritis at an earlier stage. Patients may develop choroidal neovascular membranes.
Images:

References: